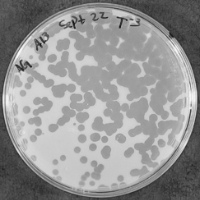

Microbacterium phage Liebestraum
Know something about this phage that we don't? Modify its data.
| Detailed Information for Phage Liebestraum | |
| Discovery Information | |
| Isolation Host | Microbacterium foliorum NRRL B-24224 |
| Found By | Angelo Giannakoulis |
| Year Found | 2025 |
| Location Found | Ottawa, Canada |
| Finding Institution | University of Ottawa |
| Program | Science Education Alliance-Phage Hunters Advancing Genomics and Evolutionary Science |
| From enriched soil sample? | No |
| Isolation Temperature | 30°C |
| GPS Coordinates | 45.390971 N, 75.637856 W Map |
| Discovery Notes | Phage Liebestraum was isolated from soil collected at Kilborn garden in Ottawa, ON. The ambient temperature at the time of collection was 20 degrees celcius. Genomic DNA was sequenced on a ONT Minion, R10.4.1 chemistry using rapid barcoding V14 and PCR amplification. The longest read was 12,879bp with 100% query cover, 99.77% identity to phage sippinontea (cluster EE). |
| Naming Notes | I named my phage Liebestraum after Franz Liszt’s piano composition Libestraum no.3. Its my faviourite romantic piano piece. |
| Sequencing Information | |
| Sequencing Complete? | No |
| Genome length (bp) | Unknown |
| Character of genome ends | Unknown |
| Fasta file available? | No |
| Characterization | |
| Cluster | Unclustered |
| Subcluster | -- |
| Annotating Institution | Unknown or unassigned |
| Annotation Status | Not sequenced |
| Plaque Notes | The plaques are circular and clear indicating a lytic phage and approximately 3mm in diameter. Further Lysogeny testing is required in order to confirm that Liebestraum is not a temperate phage. |
| Morphotype | Siphoviridae |
| Has been Phamerated? | No |
| Publication Info | |
| Uploaded to GenBank? | No |
| GenBank Accession | None yet |
| Refseq Number | None yet |
| Archiving Info | |
| Archiving status | Not in Pitt Archives |
| Available Files | |
| Plaque Picture | Download |
| Restriction Digest Picture | Download |
| Virtual Digest Picture | Download |
| EM Picture | Download |